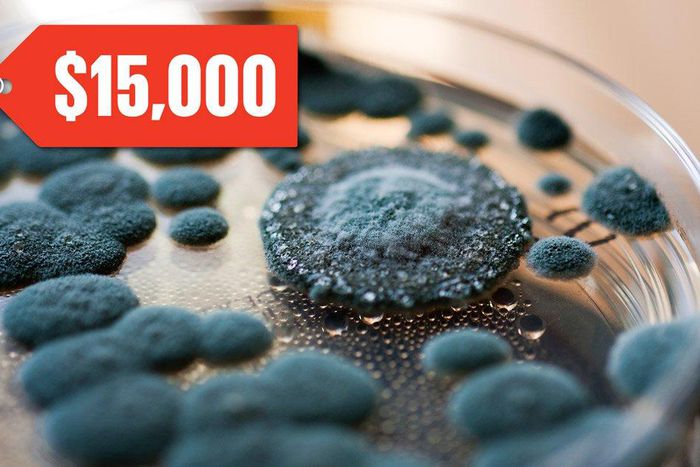
Mold

Welcome to your daily roundup of important health news
Every day, anestimated6,800 new peer-reviewed academic articles are published.
That’s a whole lot of science to wade through—but don’t fret. We’ll do the legwork for you, each and every morning.
Purchase a Piece Of Science History
Would you pay $15,000 for a dish of mold? One anonymous buyer did, shelling out $14,600 at a London auction, the Washington Post reports.
That’s because that dish of mold is actually a penicillin culture of Sir Alexander Fleming—who discovered the first antibiotic back in 1928. And if you think sharing mold cultures sounds odd, just remember that Fleming himself was quite fond of doling them out to friends and acquaintances: He once gifted one to actress Ruth Draper after seeing one of her performances, the newspaper notes.
Protect Your Ears
Over the next 40 years, the number of people with hearing loss in the U.S. is expected to spike, according to a new study from Johns Hopkins Medicine.
The researchers estimate that the numbers will gradually increase from 44 million in 2020 to 74 million by 2060.
Eat to Fuel Your Day
If you want to stop zombie-walking through your workday, the answer might be on your plate: Making smart food choices can help you be more productive at the office, the Washington Post reports.
Some tips? Make sure to eat when you’re hungry—ignoring your rumbling belly not only makes it hard to get your work done, but it can also mess up your hunger signals later on, too.
Take a lunch break, pay attention to your food (that means no multitasking when you’re eating), and stay hydrated.
Cure Sick Cell Disease?
Sickle cell disease is an inherited disorder of the red blood cells that can cause chronic pain.
Now, researchers from Paris have reversed a teenager’s sickle cell disease with the first-ever treatment of its kind to alter his DNA, the BBC reports. By altering his genetic instructions, his bone marrow now makes healthy red blood cells.
So far, the treatment has worked for 15 months—and he’s no longer on meds—but researchers are reluctant about using the word “cure,” since he’s the first patient in clinical trials.
Ease Your Aching Hands
Pain, numbness, or weakness in your wrists or hands could be carpal tunnel syndrome, a disorder which can develop due to repetitive movements. Surgery can help relieve symptoms, but now, researchers discovered that physical therapy can be just as effective for carpal tunnel syndrome, as a study in the Journal of Orthopaedic & Sports Physical Therapy discovered.
There were no differences in pain reductions, grip strength, or improvement in function between both groups.
)
)

)
)
)
)
)
)